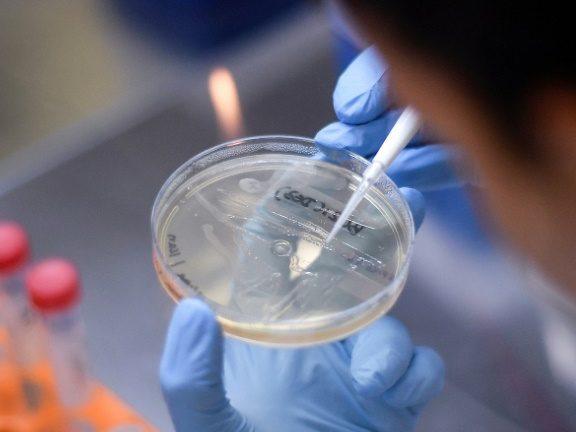

![]() |
| Foto AFP |
A Fundação Oswaldo Cruz (Fiocruz), do Ministério da Saúde, e a farmacêutica britânica AstraZeneca assinaram na sexta-feira, 31 de julho, um termo que dará base para o acordo de transferência de tecnologia entre os laboratórios e a produção de 100 milhões de doses da vacina contra a Covid-19, caso seja comprovada a sua eficácia e segurança. O medicamento está sendo desenvolvido pela empresa do Reino Unidos em conjunto com a Universidade de Oxford e já está em fase de testes clínicos no Brasil e em outros países.
O acordo entre Fiocruz e AstraZeneca é resultado da cooperação entre os governos brasileiro e britânico, anunciado em 27 de junho pelo Ministério da Saúde. A assinatura do acordo de encomenda tecnológica está prevista para a segunda semana de agosto e deve garantir o acesso a 30 milhões de doses da vacina entre dezembro e janeiro de 2021 e 70 milhões ao longo dos dois primeiros trimestres do próximo ano.
Em nota, o Ministério da Saúde informou que prevê um repasse de R$ 522,1 milhões na estrutura de Bio-Manguinhos, unidade da Fiocruz produtora de imunobiológicos, para ampliar a capacidade nacional de produção de vacinas. Outros R$ 1,3 bilhão são despesas referentes a pagamentos previstos no contrato de encomenda tecnológica. Os valores contemplam a finalização da vacina.
O memorando de entendimento assinado nesta sexta-feira, 31, define os parâmetros econômicos e tecnológicos para a produção da vacina da Covid-19 e, de acordo com o ministério, garante a incorporação da tecnologia em Bio-Manguinhos para que o Brasil tenha condições de produzir a vacina de forma independente.
A Fiocruz recebeu informações técnicas fornecidas pela AstraZeneca necessárias para a definição dos principais equipamentos para o início da produção industrial. A instituição brasileira também colocará à disposição sua capacidade técnica para a aceleração do escalonamento industrial da vacina junto a outros parceiros.
De acordo com o Ministério da Saúde, ao mesmo tempo a Fiocruz constituiu um comitê de acompanhamento técnico-científico das iniciativas associadas às vacinas para a Covid-19, com a participação de especialistas da Fiocruz e de instituições como as universidades de São Paulo (USP) e as federais do Rio de Janeiro (UFRJ) e de Goiás (UFG).
A vacina produzida por Bio-Manguinhos será distribuída pelo Programa Nacional de Imunização, que atende o Sistema Único de Saúde (SUS). O acordo com a AstraZeneca permitirá, além da incorporação tecnológica desta vacina, o domínio de uma plataforma para desenvolvimento de vacinas para prevenção de outras enfermidades, como a malária.
Com informações da Agência Brasil.
O acordo entre Fiocruz e AstraZeneca é resultado da cooperação entre os governos brasileiro e britânico, anunciado em 27 de junho pelo Ministério da Saúde. A assinatura do acordo de encomenda tecnológica está prevista para a segunda semana de agosto e deve garantir o acesso a 30 milhões de doses da vacina entre dezembro e janeiro de 2021 e 70 milhões ao longo dos dois primeiros trimestres do próximo ano.
Em nota, o Ministério da Saúde informou que prevê um repasse de R$ 522,1 milhões na estrutura de Bio-Manguinhos, unidade da Fiocruz produtora de imunobiológicos, para ampliar a capacidade nacional de produção de vacinas. Outros R$ 1,3 bilhão são despesas referentes a pagamentos previstos no contrato de encomenda tecnológica. Os valores contemplam a finalização da vacina.
O memorando de entendimento assinado nesta sexta-feira, 31, define os parâmetros econômicos e tecnológicos para a produção da vacina da Covid-19 e, de acordo com o ministério, garante a incorporação da tecnologia em Bio-Manguinhos para que o Brasil tenha condições de produzir a vacina de forma independente.
A Fiocruz recebeu informações técnicas fornecidas pela AstraZeneca necessárias para a definição dos principais equipamentos para o início da produção industrial. A instituição brasileira também colocará à disposição sua capacidade técnica para a aceleração do escalonamento industrial da vacina junto a outros parceiros.
De acordo com o Ministério da Saúde, ao mesmo tempo a Fiocruz constituiu um comitê de acompanhamento técnico-científico das iniciativas associadas às vacinas para a Covid-19, com a participação de especialistas da Fiocruz e de instituições como as universidades de São Paulo (USP) e as federais do Rio de Janeiro (UFRJ) e de Goiás (UFG).
A vacina produzida por Bio-Manguinhos será distribuída pelo Programa Nacional de Imunização, que atende o Sistema Único de Saúde (SUS). O acordo com a AstraZeneca permitirá, além da incorporação tecnológica desta vacina, o domínio de uma plataforma para desenvolvimento de vacinas para prevenção de outras enfermidades, como a malária.
Com informações da Agência Brasil.